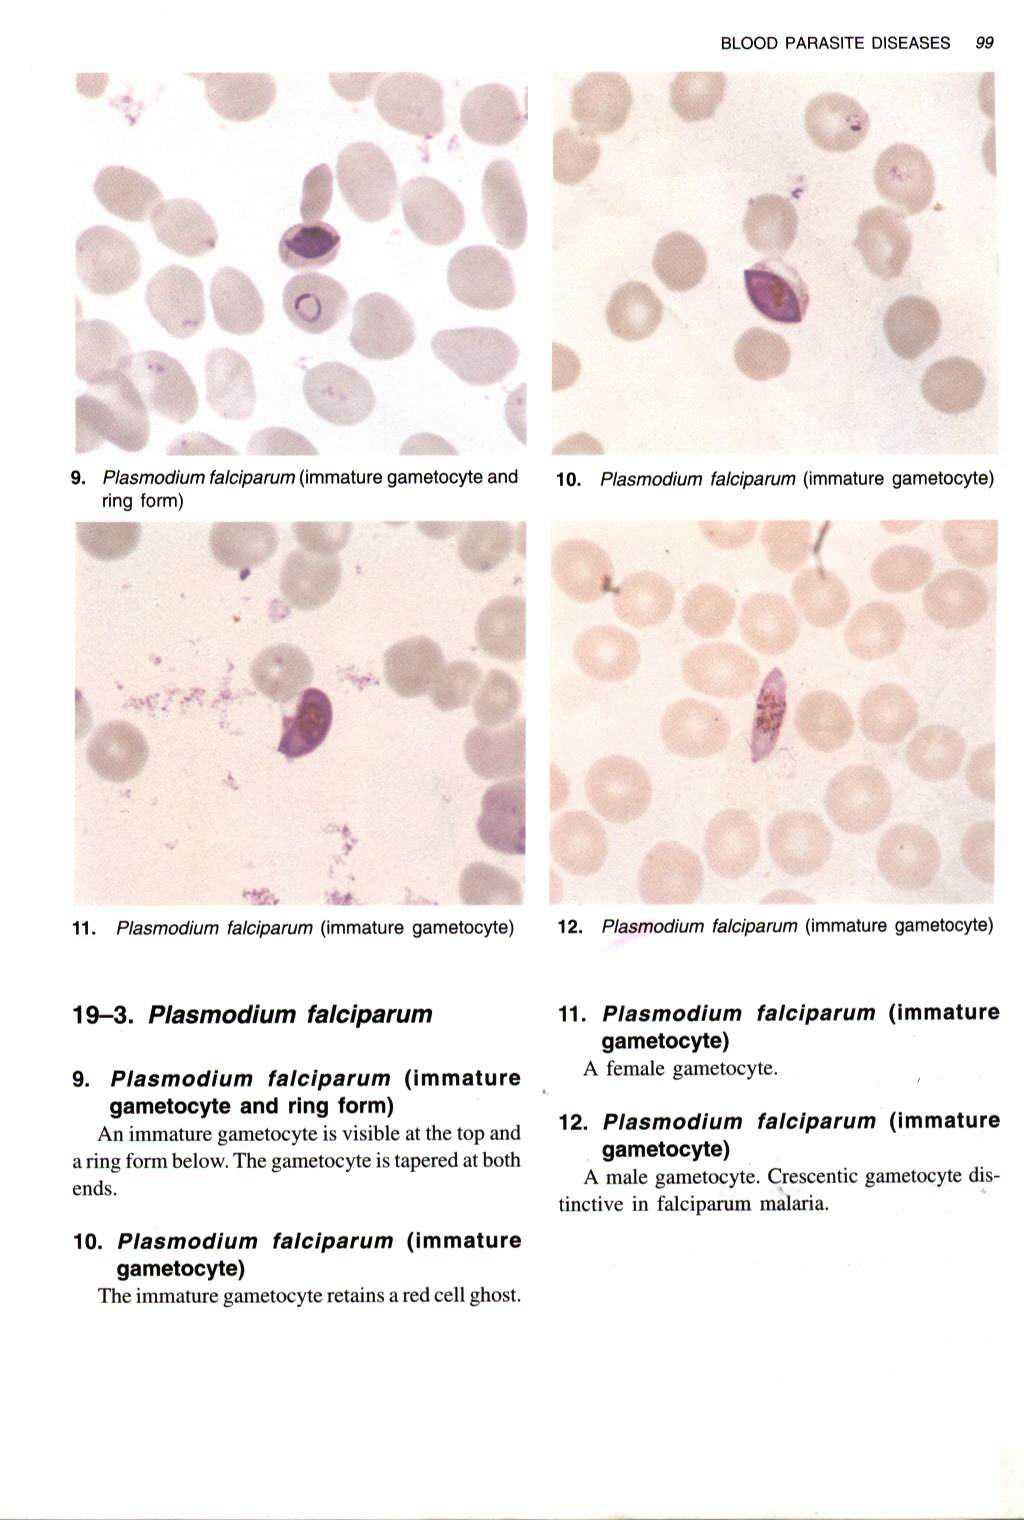
GAMBAR PLASMODIUM Yazhid Blog

Judul Kti Bakteriologi. “pemeriksaan bakteri escherechia coli pada air pdam siap minum hasil penyaringan bio energy water purifier” sebagai salah satu syarat untuk memperoleh gelar ahli madya analis kesehatan stikes insan cendekia medika jombang. Oct 06, 2014 kumpulan judul kti analis kesehatan bakteriologi identifikasi salmonella sp pada spons. Topik k3 lainnya yang bisa anda pelajari adalah contoh komunikasi vertikal, contoh buku laporan harian. Dalam menyelesaikan karya tulis ilmiah ini diajukan sebagai salah satu syarat untuk menyelesaikan pendidikan di program studi diploma tiga analis kesehatan stikes perintis padang.
 Contoh Kti Analis Kesehatan Bidang Kimia Klinik Temukan From temukancontoh.blogspot.com
Contoh Kti Analis Kesehatan Bidang Kimia Klinik Temukan From temukancontoh.blogspot.com
Karya tulis ilmiah ini dapat di simpulkan bahwa nilai mpn coliform pada sumber air di sekitar peternakan sapi dan babi tidak memenuhi standar air konsumsi secara bakteriologi jika mengacu pada permenkes ri no. Judul dapat anda modifikasi dengan perubahan tempat atau penambahan variabel atau juga dengan desain analitik dengan pendekatan komparatif atau cross sectional. 7/23/2019 kumpulan judul kti analis kesehatan 1/3kumpulan judul kti analis kesehatan (amami)friday, 24 octobr 2!4! Contoh latar belakang karya tulis ilmiah dengan judul analisais kualitas air minum secara bakteri pada depot air minum isi ulang di desa keutapang aceh besar tahun 2011. Pengaruh lama rendaman air sekam padi sebagai atraktan nyamuk aedes aegypti: Minta judul proposal kak yang mudah🙏.
Identifikasi scabies pada kambing dan sapi.
Full pdf package download full pdf package. Dentifikasi salmonella sp pada spons pencuci piring yang digunakan oleh ibu rumah tangga. Oct 06, 2014 kumpulan judul kti analis kesehatan bakteriologi identifikasi salmonella sp pada spons. Mikrobiologi, patologi klinik 📚mata kuliah diampu: 3) daya anti bakteri ekstrak bauh mahkota dewa terhadap bakteri staphylococcus aureus. Fakultas kedokteran universitas islam sultan agung:
 Source: ummpress.umm.ac.id
Judul kti analis kesehatan lengkap dengan proposal. Dentifikasi salmonella sp pada spons pencuci piring yang digunakan oleh ibu rumah tangga. Angka kuman sebelum dan sesudah mencuci tangan dengan berbagai zat aktif pada sabun mandi, sabun cuci piring dan handwash. Aktivitas ekstrak etanol daun bintaro terhadap bakteri shigella sonnei dan staphylococcus saprophyticus beserta bioautografi. Hubungan terinfeksi taenia solium pada pengonsumsi daging babi.
Source: atlm.web.id
Source: atlm.web.id
Aktivitas ekstrak etanol daun bintaro terhadap bakteri shigella sonnei dan staphylococcus saprophyticus beserta bioautografi. Efek maserat etanol daun kesumba (bixa orellana (l)) terhadap mortalitas larva nyamuk anopheles aconitus (l) 2: Sara, maid, dan icak yang impiannya adalah memberi kejutan aneh saat. Instrumentasi lab 1, bakteriologi 1, bakteriologi 2, bakteriologi 3, bakteriologi 4 dan virologi, bakteriologi 5, qc dan. 1) uji bakteriologi air minim isi ulang di kota batu dari nilai mpn coliform tahun 2010.
 Source: temukancontoh.blogspot.com
Source: temukancontoh.blogspot.com
Kumpulan judul kti analis kesehatan bakteriologi saturday 25 october 2014 1comments identifikasi salmonella sp pada spons pencuci piring yang digunakan oleh ibu rumah tangga. Bacaan sholat wudhu laher bambu vixion alek palarai cinto lirik alfa stamp lukisan anak kecil. Aktivitas ekstrak etanol daun bintaro terhadap bakteri shigella sonnei dan staphylococcus saprophyticus beserta bioautografi. 3) daya anti bakteri ekstrak bauh mahkota dewa terhadap bakteri staphylococcus aureus. Efek maserat etanol daun kesumba (bixa orellana (l)) terhadap mortalitas larva nyamuk anopheles aconitus (l) 2:

Perbedaan angka kuman pada buah apel merah di hypermat dan di pasar gede. 1) uji bakteriologi air minim isi ulang di kota batu dari nilai mpn coliform tahun 2010. Judul dapat anda modifikasi dengan perubahan tempat atau penambahan variabel atau juga dengan desain analitik dengan pendekatan komparatif atau cross sectional. Instrumentasi lab 1, bakteriologi 1, bakteriologi 2, bakteriologi 3, bakteriologi 4 dan virologi, bakteriologi 5, qc dan. Bimbingan kti bakteriologi pak didik yang selalu mendukung dan saling memberi semangat sehingga kti ini bisa selesai.
 Source: temukancontoh.blogspot.com
Source: temukancontoh.blogspot.com
Angka kuman sebelum dan sesudah mencuci tangan dengan berbagai zat aktif pada sabun mandi, sabun cuci piring dan handwash. Unknown 3 februari 2021 09.49. Penyusunan karya tulis ilmiah ini merupakan syarat akhir untuk memperoleh gelar amd di universitas setia budi. Efek maserat etanol daun kesumba (bixa orellana (l)) terhadap mortalitas larva nyamuk anopheles aconitus (l) 2: Beri masukan judul kti yang mudah dimengerti dan dilakukan.

7/23/2019 kumpulan judul kti analis kesehatan 1/3kumpulan judul kti analis kesehatan (amami)friday, 24 octobr 2!4! Identifikasi scabies pada kambing dan sapi. Menyelesaikan karya tulis ilmiah dengan judul “ identifikasi bakteri escherichia coli, staphylococcus aureus dan salmonella sp pada daging ayam yang di jual di pasar tradisional delanggu“ dengan baik. Dalam penulisan karya ilmiah, hal yang paling penting adalah susunannya harus. Penyakit tuberculosis menjadi salah satu masalah kesehatan yang paling penting di dunia.

Referensi judul penelitian mahasiswa analis kesehatan. Dalam menyelesaikan karya tulis ilmiah ini diajukan sebagai salah satu syarat untuk menyelesaikan pendidikan di program studi diploma tiga analis kesehatan stikes perintis padang. Identifikasi scabies pada kambing dan sapi. Hubungan terinfeksi taenia solium pada pengonsumsi daging babi. 3) daya anti bakteri ekstrak bauh mahkota dewa terhadap bakteri staphylococcus aureus.

Pak rudi di semarang 19 mei 2017 00.54. Sehingga penulis dapat menyelesaikan penyusunan karya tulis ilmiah dengan judul: Bantu nyari judul kti tentang bakteriologi dong kk. Sara, maid, dan icak yang impiannya adalah memberi kejutan aneh saat. Contoh latar belakang karya tulis ilmiah dengan judul analisais kualitas air minum secara bakteri pada depot air minum isi ulang di desa keutapang aceh besar tahun 2011.

Bacaan sholat wudhu laher bambu vixion alek palarai cinto lirik alfa stamp lukisan anak kecil. Pak rudi di semarang 19 mei 2017 00.54. Minta judul proposal kak yang mudah🙏. A short summary of this paper. Bacaan sholat wudhu laher bambu vixion alek palarai cinto lirik alfa stamp lukisan anak kecil.
 Source: contohproposalnew.blogspot.com
Source: contohproposalnew.blogspot.com
Kejadian infeksi pada pasien dengan diabetes mellitus lebih sering terjadikarena adanya lingkungan hiperglikemik. Instrumentasi lab 1, bakteriologi 1, bakteriologi 2, bakteriologi 3, bakteriologi 4 dan virologi, bakteriologi 5, qc dan. Dalam penulisan karya ilmiah, hal yang paling penting adalah susunannya harus. Judul dapat anda modifikasi dengan perubahan tempat atau penambahan variabel atau juga dengan desain analitik dengan pendekatan komparatif atau cross sectional. Bacaan sholat wudhu laher bambu vixion alek palarai cinto lirik alfa stamp lukisan anak kecil.
 Source: soalperhitungan.blogspot.com
Source: soalperhitungan.blogspot.com
“pemeriksaan bakteri escherechia coli pada air pdam siap minum hasil penyaringan bio energy water purifier” sebagai salah satu syarat untuk memperoleh gelar ahli madya analis kesehatan stikes insan cendekia medika jombang. Judul kti analis kesehatan lengkap dengan proposal. Dibawah ini akan kami berikan beberapa referensi terbaik yang bisa kalian pilih dan tentukan sesuai dengan keinginan dan dirasa mudah dikerjakan. Dalam menyelesaikan karya tulis ilmiah ini diajukan sebagai salah satu syarat untuk menyelesaikan pendidikan di program studi diploma tiga analis kesehatan stikes perintis padang. 7/23/2019 kumpulan judul kti analis kesehatan 1/3kumpulan judul kti analis kesehatan (amami)friday, 24 octobr 2!4!
 Source: dikdasmen.my.id
Source: dikdasmen.my.id
Hubungan terinfeksi taenia solium pada pengonsumsi daging babi. Bantu nyari judul kti tentang bakteriologi dong kk. Topik k3 lainnya yang bisa anda pelajari adalah contoh komunikasi vertikal, contoh buku laporan harian. Full pdf package download full pdf package. Form pengantar (form 035) di print sejumlah laboratorium yang akan diakses.
 Source: temukancontoh.blogspot.com
Source: temukancontoh.blogspot.com
Topik k3 lainnya yang bisa anda pelajari adalah contoh komunikasi vertikal, contoh buku laporan harian. Uji aktivitas isolat actinomycetes dari tanah sawah sebagai penghasil antibiotik. Apakah kalian saat ini sedang mencari referensi dan ide judul skripsi �� analis kesehatan kimia klinik �� ? Ilmiah ini dari awal sampai akhir dan tidak lepas dari peran dan dukungan berbagai pihak. Dalam menyelesaikan karya tulis ilmiah ini diajukan sebagai salah satu syarat untuk menyelesaikan pendidikan di program studi diploma tiga analis kesehatan stikes perintis padang.
 Source: atlm.web.id
Source: atlm.web.id
Apakah kalian saat ini sedang mencari referensi dan ide judul skripsi �� analis kesehatan kimia klinik �� ? Gambaran bakteriuria asimtomatik pada penderita diabetes mellitus di rumah sakit bhayangkara palembang tahun 2018. 3) daya anti bakteri ekstrak bauh mahkota dewa terhadap bakteri staphylococcus aureus. Kondisi ini akan menyebabkan terjadinya disfungsi sistem imun. Sara, maid, dan icak yang impiannya adalah memberi kejutan aneh saat.
 Source: pejuangskripsi88.blogspot.com
Source: pejuangskripsi88.blogspot.com
- daya anti bakteri ekstrak bauh mahkota dewa terhadap bakteri staphylococcus aureus. Kumpulan judul kti analis kesehatan mataram. “pemeriksaan bakteri escherechia coli pada air pdam siap minum hasil penyaringan bio energy water purifier” sebagai salah satu syarat untuk memperoleh gelar ahli madya analis kesehatan stikes insan cendekia medika jombang. Instrumentasi lab 1, bakteriologi 1, bakteriologi 2, bakteriologi 3, bakteriologi 4 dan virologi, bakteriologi 5, qc dan. Sara, maid, dan icak yang impiannya adalah memberi kejutan aneh saat.
 Source: atlm.web.id
Source: atlm.web.id
- perbandingan metode sahli dan metode cyanmenthemoglobin untuk penentuan kadar hb dalam darah. Peneliti tugas akhir (kti/skripsi) mengisi form permohonan (form 033) dan form pengantar (form 035) yang sudah tersedia di web kti prodi (dapat di download pada link dibawah ini), di print dan diajukan ke kepala laboratorium stikes. Judul kti analis kesehatan lengkap dengan proposal. Dibawah ini akan kami berikan beberapa referensi terbaik yang bisa kalian pilih dan tentukan sesuai dengan keinginan dan dirasa mudah dikerjakan. Ilmiah ini dari awal sampai akhir dan tidak lepas dari peran dan dukungan berbagai pihak.

- uji bakteriologi air minim isi ulang di kota batu dari nilai mpn coliform tahun 2010. 1) uji bakteriologi air minim isi ulang di kota batu dari nilai mpn coliform tahun 2010. Beri masukan judul kti yang mudah dimengerti dan dilakukan. Penyakit tuberculosis menjadi salah satu masalah kesehatan yang paling penting di dunia. Contoh halaman judul proposal kti perbedaan kadar hemoglobin pada lansia perokok dan lansia tidak perokok di desa tambakrejo tempel 3 spasi proposal karya tulis ilmiah untuk memenuhi ketentuan melakukan kegiatan penyusunan karya tulis ilmiah 3 spasi diajukan oleh.
 Source: d4tlm.stikesalirsyadclp.ac.id
Source: d4tlm.stikesalirsyadclp.ac.id
Kumpulan judul kti analis kesehatan bakteriologi saturday 25 october 2014 1comments identifikasi salmonella sp pada spons pencuci piring yang digunakan oleh ibu rumah tangga. Oct 06, 2014 kumpulan judul kti analis kesehatan bakteriologi identifikasi salmonella sp pada spons. 7/23/2019 kumpulan judul kti analis kesehatan 1/3kumpulan judul kti analis kesehatan (amami)friday, 24 octobr 2!4! Kumpulan judul kti analis kesehatan mataram. Menyelesaikan karya tulis ilmiah dengan judul “ identifikasi bakteri escherichia coli, staphylococcus aureus dan salmonella sp pada daging ayam yang di jual di pasar tradisional delanggu“ dengan baik.
This site is an open community for users to do sharing their favorite wallpapers on the internet, all images or pictures in this website are for personal wallpaper use only, it is stricly prohibited to use this wallpaper for commercial purposes, if you are the author and find this image is shared without your permission, please kindly raise a DMCA report to Us.
If you find this site serviceableness, please support us by sharing this posts to your favorite social media accounts like Facebook, Instagram and so on or you can also bookmark this blog page with the title judul kti bakteriologi by using Ctrl + D for devices a laptop with a Windows operating system or Command + D for laptops with an Apple operating system. If you use a smartphone, you can also use the drawer menu of the browser you are using. Whether it’s a Windows, Mac, iOS or Android operating system, you will still be able to bookmark this website.





